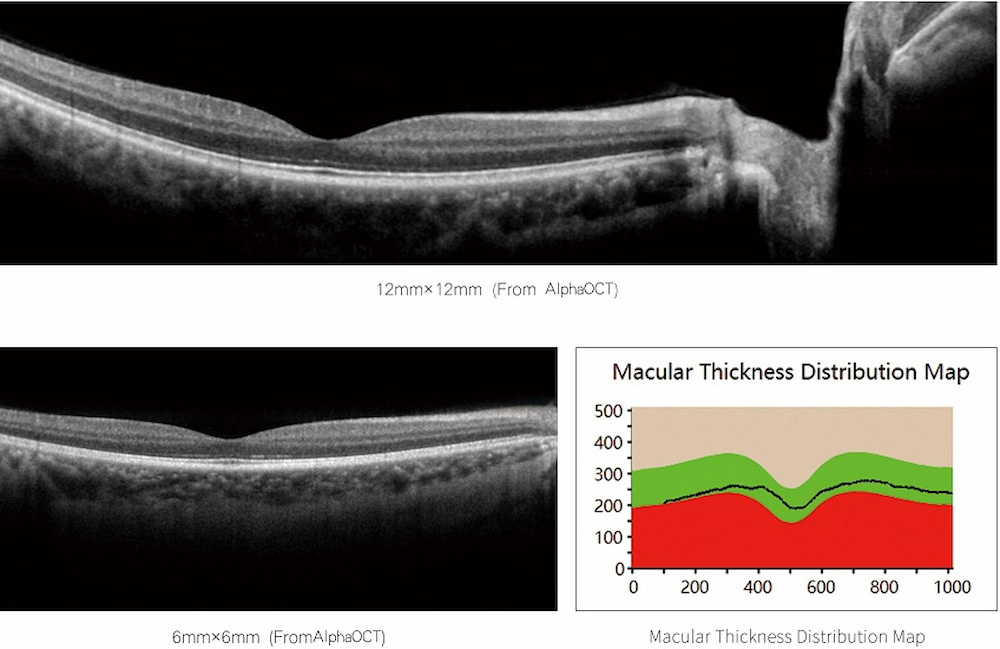

عندما يلتقي التصوير المقطعي البصري بالذكاء الاصطناعي، تصل ثورة التشخيص بهدوء:
التعرف التلقائي على الآفات: يمكن للخوارزمية القائمة على الشبكة العصبية التلافيفية (CNN) إكمال التحليل المرضي لصور التصوير المقطعي البصري للعين في غضون 0.3 ثانية، وتحديد العشرات من الآفات مثل الثقوب البقعية وانفصال الشبكية، مع معدل دقة يتجاوز 95٪
التوجيه الجراحي الفوري: أثناء جراحة الأورام، يُمكن لنظام التصوير المقطعي البصري المُحسّن بالذكاء الاصطناعي تحديد حدود الورم ديناميكيًا. تُظهر البيانات التجريبية أن هذا يُقلل من معدل الأنسجة الخبيثة المتبقية بنسبة 40%.
اختراق في مجال التصوير المرن: نجحت تقنية إعادة بناء إجهاد الشبكة العصبية البايزية التي طورها فريق من جامعة قوانغدونغ للتكنولوجيا في حل مشكلة قياس الإشارات المتعلقة بالانحدار الكروماتوغرافي، مما يتيح للتصوير المقطعي البصري رسم خريطة للخصائص الميكانيكية للأنسجة وتوفير بُعد جديد لتشخيص صلابة السرطان.
ركن المعرفة: لغز "التماسك" في التصوير المقطعي البصري
التداخل منخفض التماسك (LCI) هو التكنولوجيا الأساسية لـ
أكتوبر
عندما يلتقي شعاع الضوء المنعكس من النسيج بشعاع الضوء المرجعي، لن يتداخل إلا الضوء الذي يقل فرق مساره البصري عن طول تماسك مصدر الضوء. بقياس إشارات التداخل، يمكن لتصوير OCT تحديد عمق المشتتات بدقة - تمامًا كما هو الحال عند قياس عالم الحياة المجهري باستخدام "مسطرة" ضوئية.

التصوير المقطعي البصري كامل المجال (FF-OCT): تجاوز حدود الدقة التقليدية، محققًا تصويرًا ديناميكيًا على مستوى الخلية. في جراحة سرطان الثدي، تمكن النظام التجريبي من تحديد وجود خلايا سرطانية متبقية عند حافة الاستئصال خلال 20 ثانية.
مصدر ضوء على مستوى الشريحة: طورت جامعة كولومبيا شريحة مصدر ضوء فائق الاستمرارية على مستوى المليمتر، لتحل محل الليزر الضخم التقليدي وتمهد الطريق لأجهزة OCT المحمولة
دمج متعدد الوسائط: دمج التصوير المقطعي البصري مع التصوير الضوئي الصوتي والمجهر الفلوري وتقنيات أخرى للحصول في آنٍ واحد على المعلومات الثلاثية للبنية والوظيفة والجزيء. على سبيل المثال، في أبحاث علوم الدماغ، يمكن لهذه الأنظمة مراقبة ديناميكا الدم والأنشطة العصبية بالتوازي.

وعلى الرغم من الآفاق المشرقة، لا تزال تقنية OCT تواجه قيوداً عملية:
حدود عمق الاختراق: إن خصائص التشتت القوية للضوء في الأنسجة البيولوجية تحد من عمق الكشف الفعال إلى 2-3 مم (الجلد) إلى 2-3 سم (العين).
تحدي محيط البيانات: إن فحص التصوير المقطعي البصري لكامل الجلد في الجسم يولد بيانات على مستوى GB، ويجب تطوير خوارزميات تحليل ضغط أكثر ذكاءً
معضلة التوحيد القياسي: تؤدي الاختلافات في معلمات المعدات بين الشركات المصنعة المختلفة إلى انخفاض في قابلية مقارنة البيانات، ومن الضروري إنشاء نظام مراقبة الجودة عبر الأنظمة الأساسية

بينما لا تزال أحدث الأبحاث المنشورة تستكشف كيفية تحسين نموذج الذكاء الاصطناعي للتصوير المقطعي البصري (OCT)، بدأ المبتكرون في الخطوط الأمامية للمجال السريري بإعادة صياغة مصائر المرضى باستخدام هذه التقنية. من آفات الشبكية الدقيقة إلى اللويحات القاتلة في الشرايين التاجية، ومن الخلايا السرطانية تحت الجلد إلى الانتفاخات الدقيقة للألياف العصبية - هذا الضوء الخافت للتصوير المقطعي البصري، الذي يخترق ضباب الحياة، يُعيد تشكيل الحدود المعرفية للطب الحديث بهدوء.
مرحبا بكم أيضا
اتصل بنا
، نحن
شركة زد دي الطبية
.
هاتف: +86-187 9586 9515
بريد إلكتروني :
sales@zd-med.com
واتساب/جوال: +86-187 9586 9515